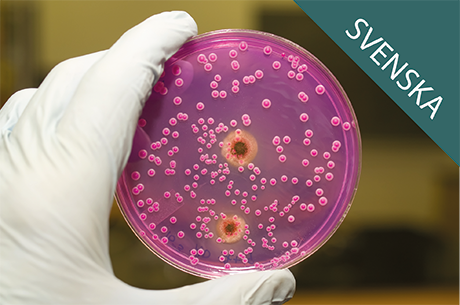
prod01

Renrumskurs Online
Syfte
Mikrobiologi för icke-mikrobiologer är avsedd för alla som saknar formell kompetens inom ämnesområdet mikrobiologi, och som trots detta, på ett eller annat sätt, kommer i kontakt med mikrobiologiska begrepp och uttryck. Exempelvis operatörer, arbetsledare, laboratoriepersonal, underhållspersonal, samt alla som på ett eller annat sätt kommer i kontakt med mikrobiologi.
Innehåll
Kursen består av 6 delmoment med kontrollfrågor efter varje delmoment.
Kursens längd
Kursens beräknade längd är ca 1 timme och 30 minuter, med föreläsningsdelar på sammanlagt 68 minuter, kontrollfrågor efter varje delmoment samt en kort utvärdering.
Betalning och Giltighet
Frågor?
Kontakta oss på sales@mcleaned.com för mer information.
Kompletterande kurs
Komplettera gärna med vår kurs "Rengöring och desinfektion av renrum - Del 1", där vi fördjupar oss i de teoretiska delarna av rengöring och desinfektion. Läs mer om kursen här
> Se hela vår kurslista
* 1 kurslicens per kursdeltagare och kurs
** VISA med Verified by VISA, eller MasterCard med MasterCard SecureCode
*** Vid godkänd förfrågan får ni en offert och mer information via epost
Course Content
|
1. Mikrobiologiska ord och uttryck
|
13min |
|
2. Namngivning och systematik
|
6min |
|
3. Analys och bestämning av mikroorganismer
|
14min |
|
4. Mikrobiologisk luftprovtagning
|
14min |
|
5. Mikrobiologisk ytprovtagning
|
9min |
|
6. Mikrobiologiska Gränsvärden
|
12min |
1. Pay by credit card and assign
1. Pay by credit card and assign 2. Get instant access to
2. Get instant access to  3. Download the personalised
3. Download the personalised